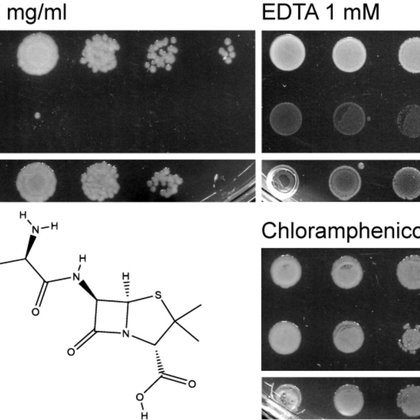
Tweet card summary image

James Connolly
@RuaMicro
Followers
1K
Following
6K
Media
28
Statuses
3K
MRC Career Development Fellow at Newcastle University. Studying how pathogens control their genes
Newcastle Upon Tyne, England
Joined June 2018
I’m thrilled to share our latest work in @NatureComms led by the brilliant @curtiscottam and the first paper from his PhD. He discovered a new arabinose transporter in EHEC and found that metabolism of this sugar enhances T3SS expression
9
18
79
Our recent work is now published @NatureComms and concludes a really great project started during my PhD. In summary, we identify two unique mechanisms of D-ribulose utilisation in distinct A/E pathogens for the first time! Check it out
nature.com
Nature Communications - Cottam et al. identify distinct pathways for D-ribulose utilisation in pathogenic Escherichia coli and Citrobacter rodentium, providing mechanistic details and suggesting...
1
5
13
Very pleased to present the next pre-print from our lab #glycotime We showcase PNGaseL from Flavobacterium akiainvivens that we hope will be a useful tool for the glyco community 🍬🧪👩🔬 Special shout out to @CassieBakshani and Paulina (Ludger) https://t.co/3uK0cqogjw
biorxiv.org
PNGases are used by a wide range of organisms to remove N-glycan structures from proteins for use as either nutrients or in glycoprotein processing. PNGaseF is the most well-characterised enzyme of...
1
6
16
Looking to appoint a new or experienced Postdoc to join my team. Investigating novel therapeutics targeting Crohn's disease associated bacteria. Background in Microbiology, Immunology, Biochemistry or related field. 🦠🔬 Apply here: https://t.co/ESiYigitoH Closes 31st May 2025
3
25
53
Postdoc position available! This is a 2-year post funded by the Academy of Medical Sciences. You'll be based in the Centre for Bacterial Cell Biology here in Newcastle, using super-resolution microscopy to look at the bacterial cell wall. 🔬🦠 RT 🙏 https://t.co/qFgp19Vz5Y
0
14
17
If you are interested in phage satellites, we hope you'll enjoy this. Fun collaboration with the Rocha, Seed, Bikard, and Chen labs! https://t.co/8HC4xs6hdE
nature.com
Nature Reviews Microbiology - In this Review, Penadés et al. explore the genetics, potential origins and life cycle of phage satellites, and they discuss the impact of these elements on the...
0
39
141
Still time to apply for this PhD position with our team!
Fully funded PhD position available to join our team! We will focus on untangling the mechanisms used by antibiotic resistant E.coli to colonise the host gut. Highly interdisciplinary project with Karrera Djoko and @BanzhafLab. Please share
0
6
6
Come and do a PhD with me and @DrPaulJamesUK to find some new exciting enzymes! #glycotime
https://t.co/d35dheS6Sf
findaphd.com
PhD Project - New lysins for medically and environmentally important Mycobacteriales at Newcastle University, listed on FindAPhD.com
0
8
9
Fully funded PhD position available to join our team! We will focus on untangling the mechanisms used by antibiotic resistant E.coli to colonise the host gut. Highly interdisciplinary project with Karrera Djoko and @BanzhafLab. Please share
findaphd.com
PhD Project - Microbial metal-head: the integrated roles of metal homeostasis in host-pathogen interaction at Newcastle University, listed on FindAPhD.com
0
29
33
The lab is now up and running at New England Biolabs @NEBiolabs! I'm looking for a postdoc to study phage defence systems. If you'd like the academic freedom to publish but the resources of industry, then take a look 🤓😃
6
52
152
#mBio is proud to announce that our new Editor in Chief, beginning July 1, 2025, is Dr. Marvin Whiteley! https://t.co/VQHa9kxNyi. He will build on the incredible & visionary work done by our Founding EIC, Dr. Arturo Casadevall. @whiteleylab @ACasadevall1
asm.org
ASM welcomes new Editors in Chief (EiC) for the Journal of Clinical Microbiology®, mBio®; mSystems® and mSphere®.
5
14
68
Love phage-bacteria interactions, anti-phage systems, and a sprinkle of evolutionary biology? There’s still time to apply and join our team in Glasgow at @UofGSii !
🚨We are hiring! A MRC-funded PDRA position to study novel anti-phage systems & their evolutionary dynamics in P. aeruginosa, in collaboration with @friendlymicrobe. If you are passionate about phage-bacteria interactions & evolution, apply now !
1
16
34
We're hiring! Two new fellowships available in AMR at the UCD School of Medicine and the Vet School https://t.co/BDZeL59tPb
0
11
23
🚨We are hiring! A MRC-funded PDRA position to study novel anti-phage systems & their evolutionary dynamics in P. aeruginosa, in collaboration with @friendlymicrobe. If you are passionate about phage-bacteria interactions & evolution, apply now !
1
37
73
Apply now, spread the word: three (3) fully funded Helmholtz research groups (assistant prof level) with attractive packages. Topics: RNA-based medicine, microbial RNA, and RNA-based infection research incl. RNA technologies. Great environment for young people. Come and join us.
3
72
138
Over the moon to share some amazing news—I’ve been awarded an MRC Career Development Award to pursue my research at the University of Glasgow @UofGSii ! 🎉 Can’t wait to get started on this exciting new chapter. Stay tuned—I’ll soon be advertising a PDRA position!
9
8
63
OmpA controls order in the outer membrane and shares the mechanical load
pnas.org
OmpA, a predominant outer membrane (OM) protein in Escherichia coli, affects virulence, adhesion, and bacterial OM integrity. However, despite more...
0
2
18
Giving these another airing... projects on bacterial pathogens, antimicrobial resistance, and basic mechanisms... all with a hint of gene regulation #PhD #opportunities
PhD projects available in our lab all listed in the below link. All focus on bacterial gene regulation, in the context of basic understanding, disease, or anitbiotic resistance. Deadlines in January... https://t.co/G5sWOdIohF
1
19
17
Exciting times! Our latest preprint is now live 🤩! I truly believe this is one of the most significant contributions we've made. It offers fresh hypotheses about how pandemic Vibrio cholerae spreads globally. Let’s dive in!🧵..1/n https://t.co/1SfPNSzJsd
biorxiv.org
Our understanding of the factors underlying the evolutionary success of different lineages of pandemic Vibrio cholerae remains incomplete. Interestingly, two unique genetic signatures define the West...
8
38
136
PhD projects available in our lab all listed in the below link. All focus on bacterial gene regulation, in the context of basic understanding, disease, or anitbiotic resistance. Deadlines in January... https://t.co/G5sWOdIohF
findaphd.com
1
15
25
Officially Dr Githwe 👩🏾🎓🥂an incredible 4 years finished off in the most perfect way! I’m honoured to have had the most wonderful discussion with my examiners @NclFungalGroup @nkoropatkin. Thank you for all of your kind words + allowing me to geek out about such a fun project 🦠
6
5
52